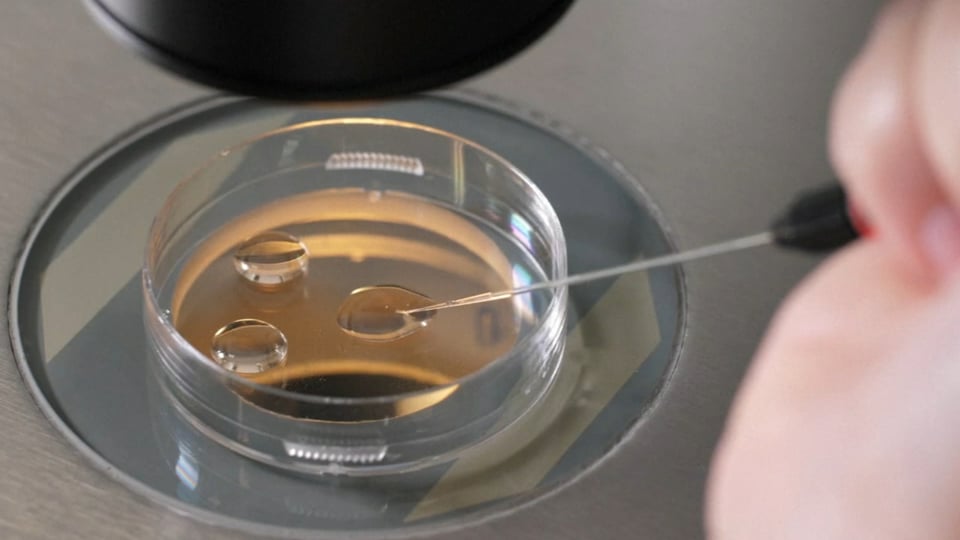

Thursday,February 22, 2024. Annette’s News Roundup.
I think the Roundup makes people feel not so alone.
To read an article excerpted in this Roundup, click on its blue title. Each “blue” article is hyperlinked so you can read the whole article.
Please feel free to share.
Invite at least one other person to subscribe today! https://buttondown.email/AnnettesNewsRoundup
____________________________________________
Joe is always busy.
UPDATE: Our Administration just cancelled student debt for over 150,000 borrowers currently enrolled in the SAVE plan.
— The White House (@WhiteHouse) February 21, 2024
In total, our Administration has now approved nearly $138 billion in student debt cancellation for almost 3.9 million borrowers through various actions. pic.twitter.com/ftNjIwqGe9
Biden goes off on GOP Congress at a fundraiser tonight: "I've been a senator since '72. I've served with real racists. I've served with Strom Thurmond. I've served with all these guys that have set terrible records on race. But guess what? These guys are worse. These guys do not believe in basic democratic principles."
(Quote comes via White House pool report.)
BREAKING: President Biden just announced $200 million in grants for registered apprenticeship programs around the country. Retweet to ensure all Americans hear about these opportunities. pic.twitter.com/qCwfAchlo8
— Biden’s Wins (@BidensWins) February 21, 2024
In its surprising editorial favoring Joe Biden, the Houston Chronicle’s Editorial Board easily dispatches the bad faith attacks on Biden's age, saying that he has "forgotten more than his presumed Republican rival will ever know. That's not saying much, and at the same time, it says it all."
____________________________________________
Kamala is always busy.
Congressman John Lewis was an American hero—a giant whose shoulders upon which we stand.
— Kamala Harris (@KamalaHarris) February 21, 2024
Today, on what would have been his 84th birthday, we honor him by continuing his fight to protect and strengthen our democracy. pic.twitter.com/df3fG0W9ZV
____________________________________________
“Alabama’s gotten me so upset.”
After Ruling, University of Alabama at Birmingham Health System Pauses I.V.F. Procedures.
The U.A.B. system said it was worried about potential criminal prosecutions after Alabama’s Supreme Court ruled that frozen embryos should be considered children.
The University of Alabama at Birmingham health system announced on Wednesday that it was pausing in vitro fertilization treatments as it evaluated the Alabama Supreme Court’s ruling that frozen embryos should be considered children.
“We are saddened that this will impact our patients’ attempt to have a baby through I.V.F.,” a statement from the health system said, “but we must evaluate the potential that our patients and our physicians could be prosecuted criminally or face punitive damages for following the standard of care for I.V.F. treatments.”
The health system’s Division of Reproductive Endocrinology and Infertility will continue performing egg retrievals from women seeking fertility treatment, the statement said, but it will not undertake the next steps in the process — combining the eggs with sperm in a lab for fertilization, and allowing embryos to develop — for now.
“Everything through egg retrieval remains in place,” the statement said. “Egg fertilization and embryo development is paused.”
In response to a question, a spokesperson for the health system said that embryo implantation procedures, the final part of the I.V.F. process, had also been paused.
The health system includes the University of Alabama at Birmingham Hospital, the largest hospital in the state and, according to its website, among the 20 “largest and best equipped” hospitals in the country.
(New York Times).
Opinion: The twisted irony in Alabama’s court decision on embryos.
The Alabama Supreme Court’s ruling on Friday will transform infertility care across the state, potentially setting the stage for a ruling that a fetus or even an embryo outside the womb holds constitutional rights.
The ruling is a reminder of how important fetal personhood is becoming for both the antiabortion movement and the Republican Party — and of its potentially drastic consequences. In the United States today, recognizing the value of an embryo or fetus sets a precedent that no state can permit access to abortion — and that anyone who chooses abortion may be committing a crime.
The irony in the Alabama court’s decision is that more Americans who want to be parents will be unable to achieve that dream. The ruling is extraordinary not only in declaring personhood before birth but also in applying the idea to embryos that haven’t been implanted in the uterus. But the ruling is not just bizarre; its consequences may be profound.
If an embryo is a person, it can no longer be destroyed, donated for research or potentially even stored. Some abortion opponents argue that if embryos are persons, each one that is created must be implanted — and that would make even storing embryos for future use impermissible. If any of that comes to pass — and in Alabama, it likely will — that will transform how in vitro fertilization (IVF) works, and will mean a lower rate of success for Americans who already struggle to start a family.
The court’s ruling could set a precedent for other conservative states that embrace the idea of personhood before birth, making it harder to pursue IVF across large swaths of the country. The decision will also bolster a broader antiabortion effort to recognize a fetus in the womb or even a frozen embryo as a person under federal constitutional law, helping abortion opponents make the case that if states already sometimes treat an embryo or fetus as a rights-holder, constitutional law should do the same.
The Alabama case began when three couples visited a fertility clinic in Mobile to pursue IVF: a treatment in which multiple eggs are harvested, fertilized and implanted to create a pregnancy. Across the US annually, about 2% of births involve IVF. The success rate of each IVF cycle can be low given the age and previous medical condition of the patient.
Since many patients who turn to fertility clinics experience trouble getting pregnant, physicians routinely create and store excess embryos so that patients can try again if a first attempt fails. IVF is also expensive — an average cycle can cost anywhere between $12,000 and $30,000, even when patients can use embryos they’ve already created. This means that patients have more embryos than they implant in a given cycle, which they can choose to store, give to other patients or donate for research.
The three Alabama couples elected to store their excess embryos at the Mobile clinic from 2013 to 2016. In December 2020, however, a patient from an attached hospital entered the clinic, handled some of the embryos and injured their hand, given the subzero temperatures at which the embryos are stored. As a result, they dropped the embryos and accidentally destroyed them.
The plaintiffs sued, first alleging that the clinic was negligent in how it monitored the embryos, contending that the clinic breached the contract it signed with the couples. The couples also had a much more controversial claim: that their embryos counted as “children” or “persons” under the state’s wrongful death of a minor law.
The Alabama Supreme Court agreed that the embryos were persons. The court pointed to a 2018 ballot measure that recognized fetuses as persons under state law. “The People of this State,” the court explained, “have adopted a Constitutional amendment directly aimed at stopping courts from excluding ‘unborn life’ from legal protection.” It did not matter to the court that the embryos were frozen and not yet implanted in the uterus.
In a concurring opinion, Chief Justice Tom Parker suggested that divine law — which, he claimed, had been embraced by the people of Alabama — supported the court’s conclusion. “Human life,” he stressed, “cannot be wrongfully destroyed without incurring the wrath of a holy God.”
The Alabama ruling is a reminder of the importance of personhood politics on the American right — and a warning about how punitive they have become. Since the US Supreme Court overturned Roe v. Wade in 2022, the fight to establish that the word “person” in the 14th Amendment of the US Constitution applies to fetuses has escalated. At the one-year anniversary of the reversal of Roe, leading groups from the Alliance Defending Freedom to Students for Life called for personhood for “preborn children.”
States are considering bills recognizing the personhood of fetuses in contexts from wrongful death to tax deductions. The goal is to slowly build the case that a fetus or even an embryo is a person for every purpose and circumstance. For the antiabortion movement, that would mean that no state could allow legal abortion. For some self-proclaimed antiabortion abolitionists, fetal personhood would mean that the criminal law would have to punish women who terminate their pregnancies.
In theory, there should be a way for Americans like the couples in the Alabama case to protect themselves against medical negligence — or even to express their belief that frozen embryos or life in the womb have value — without setting a precedent for criminalizing abortion across the US. There are plenty of examples of people asserting that fetal life matters who are not angling to criminalize reproduction. A pregnant woman tried to drive in the HOV lane, arguing that her unborn child is a person. A prison employee in Texas sued on similar grounds when her child was stillborn after she was not allowed to leave her post.
In the context of reproduction and the law, there are gaps in protections for Americans who experience stillbirth or miscarriage as a result of medical negligence, or who are otherwise denied wanted parenthood. Polls suggest that many Americans believe life in the womb has value while opposing criminal abortion bans: A 2022 Pew Forum poll found that even about a third of Americans who think abortion should be legal believe that “human life begins at conception, so a fetus is a person with rights.”
That would not seem so strange if there was a way to recognize the value of embryonic or fetal life that does not inexorably lead to the punishment of physicians who perform abortions, others who aid abortion seekers and even abortion seekers themselves. It is not impossible to imagine how that would look — the Constitutional Court of South Korea took a position like this in recognizing constitutional protection for abortion rights in 2019.
If embryonic or fetal life has value, the state shouldn’t start with criminalization. Instead, the government may have a constitutional obligation to advance its interest in protecting that life in ways that don’t limit reproductive liberty, by protecting pregnant workers, delivering better prenatal care or safe housing and reducing the rate of maternal mortality.
There is nothing inevitable about equating criminalization with valuing fetal or embryonic life, or providing a remedy for people who want to become parents and are unfairly denied the chance to do it.
The Alabama Supreme Court’s ruling is just the start of the push for fetal personhood. And unless something changes, the more fetal personhood is recognized, the more kinds of reproductive decision-making will be a crime. (CNN- Mary Ziegler is the Martin Luther King Jr. Professor of Law at UC Davis. She is the author of “Dollars for Life: The Antiabortion Movement and the Fall of the Republican Establishment” and “Roe: The History of a National Obsession.”)
Never get confused about who Nikki Haley is.
NEW: Nikki Haley tells me that frozen embryos created through in-vitro fertilization “are babies,” siding with a recent AL decision that raised concerns among doctors and patients worried about the future of the procedure. w/ @Rhoades31 @NBCNews https://t.co/8mgqqP4GtN
— Ali Vitali (@alivitali) February 21, 2024
Democrats are the party of family.
It's time for every man to speak out about what is happening in Alabama & the war on women's bodies. It's time for all of us—no matter what our gender is—to call out extreme abortion bans and IVF bans. An attack on women is an attack on all of us. Men, be loud about this, please.
— Victor Shi (@Victorshi2020) February 21, 2024
A vote for Donald Trump is a vote for a national abortion ban. Pass it on.
— Hillary Clinton (@HillaryClinton) February 21, 2024
This decision is outrageous—and it is already robbing women of the freedom to decide when and how to build a family. https://t.co/N04pReaM2B
— Kamala Harris (@KamalaHarris) February 21, 2024
____________________________________________
What Trump has done to this country.
Arizona Refuses to Send Murder Suspect to New York Over Bragg’s Policies.
The Maricopa County attorney in Arizona said she would fight to keep a man who authorities believe bludgeoned a woman to death in a New York City hotel.

On Feb. 8, a woman was found dead in a Manhattan hotel room, bludgeoned to death with an iron.
This week, the police announced that a 26-year-old man suspected of committing the crime had been arrested in Arizona, where he was accused of stabbing another woman a few days after the homicide in New York. A Manhattan prosecutor flew to Arizona to discuss bringing the man back to face charges.
In most homicide cases across the country, it would be a routine extradition. But on Wednesday, an Arizona prosecutor refused, saying she did not believe Alvin L. Bragg, Manhattan’s district attorney, could be trusted to keep him behind bars.
Rachel Mitchell, the Maricopa County attorney, said at a news conference on Wednesday that her team would not work with Mr. Bragg, whose office is seeking to charge the man, Raad Almansoori, in the killing of 38-year-old Denisse Oleas-Arancibia.
“Having observed the treatment of violent criminals in the New York area by the Manhattan D.A. there, Alvin Bragg,” Ms. Mitchell told reporters, “I think it’s safer to keep him here and keep him in custody, so that he cannot be out doing this to individuals either in our state, county, or anywhere in the United States.”
With that statement, which a spokeswoman later tried to temper, a local New York City story was swept into a national debate over politics and crime, a cyclone fanned by Mr. Bragg’s prosecution of former President Donald J. Trump on charges that he orchestrated the cover-up of a hush-money payment to a porn star in an attempt to conceal her story of an affair before the 2016 election.
Both prosecutors have national profiles: Ms. Mitchell, a Republican, was tapped in 2018 to play a key role in the Senate confirmation hearings of one of Mr. Trump’s Supreme Court nominees. Mr. Bragg, a Democrat, has been a lightning rod for complaints by Mr. Trump and his supporters that he is being persecuted as he seeks another term in the White House.
Emily Tuttle, a spokeswoman for Mr. Bragg, called Ms. Mitchell’s statement a grave insult.
“It is deeply disturbing that D.A. Mitchell is playing political games in a murder investigation,” Ms. Tuttle said in a statement. She also noted that killings and shootings had dropped since Mr. Bragg took office.
“New York’s murder rate is less than half that of Phoenix, Ariz., because of the hard work of the N.Y.P.D. and all of our law enforcement partners,” Ms. Tuttle said.
“It is a slap in the face to them and to the victim in our case to refuse to allow us to seek justice and full accountability for a New Yorker’s death.”
Since the beginning of his term in 2022, Mr. Bragg has drawn criticism for his handling of crime in the nation’s most populous city. Police unions and Republican officials have complained that too many dangerous people are being released on bail before trial, and that Mr. Bragg has failed to prosecute them as aggressively as he might. But there was no indication that Mr. Bragg’s office would not seek to keep the hotel-killing suspect behind bars.
The crimes in Arizona were also serious.
After workers discovered the body of Ms. Oleas-Arancibia in a room at the SoHo 54 Hotel on Feb. 8, Mr. Almansoori flew to Arizona, New York police officials said on Wednesday.
Nine days after Ms. Oleas-Arancibia’s body was discovered, Mr. Almansoori committed a carjacking in Phoenix, stabbing the woman who was driving, the police said. Then, on Feb. 18, Mr. Almansoori walked into a McDonald’s in Surprise, Ariz., dragged a woman into a bathroom and stabbed her several times, New York police officials said. Mr. Almansoori was arrested in Scottsdale, Ariz., while driving a stolen car.
He has been in custody in Maricopa County since.
In an email after the Wednesday news conference, a spokeswoman for Ms. Mitchell said Mr. Almansoori was not being extradited because the charges there were grave and state law required them to be adjudicated before extradition.
Another spokeswoman, Jeanine L’Ecuyer, said Mr. Bragg had not formally requested an extradition, and that Maricopa County prosecutors had not met with any of their Manhattan counterparts.
Ms. Tuttle, the Manhattan district attorney’s spokeswoman, declined to say precisely what Mr. Bragg would do next, but she did say that he would not relent.
Members of the Republican Party have regularly tried to embarrass Mr. Bragg, who is set to try Mr. Trump’s criminal case beginning next month.
After Mr. Trump was indicted in Manhattan in the hush-money case last March, prominent Republicans including Representative Jim Jordan of Ohio, the chairman of the House Judiciary Committee, held a hearing that they said would highlight crime in New York City. They painted Mr. Bragg as a hypocrite who was focused on a political crusade rather than bad behavior in his backyard.
Ms. Mitchell became the county’s top prosecutor in a 2022 special election and is currently running for a second term. On her campaign website she inveighs against President Biden and big cities that she claims “turn a blind eye to rising crime.”
“Rachel Mitchell is a lifelong conservative and a veteran prosecutor with a record of enforcing the rule of law, locking up criminals and keeping our community safe,” according to her website.
Ms. Mitchell gained national attention for her persistent and probing questioning of Christine Blasey Ford on behalf of fellow Republicans during the 2018 confirmation hearings for Supreme Court Justice Brett M. Kavanaugh.
Ms. Ford had accused Mr. Kavanaugh — a Trump nominee — of sexually assaulting her decades before, and the move to use Ms. Mitchell for questioning was seen by some as a way to insulate Republican senatorson the Judiciary Committee, all men, from attacking Ms. Ford.
Before that hearing, Ms. Mitchell had built a reputation by avidly pursuing cases like sexual assault and child molestation, while also lobbying for tougher laws governing such crimes.
Her comments Wednesday about Mr. Bragg, seen by many in her party as a nemesis of the former president, may carry special weight in her state. Arizona and its Republican Party were torn by battles over false claims that the election there was thrown to Joseph R. Biden Jr. by fraud.(New York Times).
____________________________________________
Meet Shirley Simson.
Granny style: Can an 84-year-old make the WNBA? She’s got their attention.

Shirley Simson, an 84-year-old mother of four, grandmother of 14 and great-grandmother of 10, stood inside the lobby of Las Vegas’ Bellagio Hotel & Casino on an early January afternoon waiting for her ride. She wore bright pink athletic shorts with the phrase “SPORT DRIP” printed all over, a white single-leg sleeve running down her left side, a white shooting sleeve on her right arm and a white headband with “CANDY” in its center tying back her gray hair. Alongside two of her grandchildren, Shirley planned on making a 20-minute trip to Henderson, Nev., where the Las Vegas Aces are headquartered. She hoped to work out inside the WNBA team’s facility.
Before the trio departed, a teenager — “a young lad,” in Simson’s words — spotted her near the hotel’s entrance and asked for a photo. She had never been stopped like that before. She was surprised, but she obliged anyway.
Simson has lived almost all her life in obscurity. For around four decades, she was a registered nurse in southern British Columbia, Canada. Now retired, she gardens, plays bridge, creates stone sculptures and participates in two book clubs. Despite her age and height — she was once 5-foot-6 but says she’s shrunk to 5-4 — Simson is also a basketball player. Or, rather, she is trying to be one.
She’s hoping to become a WNBA All-Star. “To me, life is worth living,” Simson says. “I just think you should make the most of it because you’re only here for a certain length of time.”
In mid-October, Simson’s journey to the professional ranks began. Her grandchildren, Parker, 25, and Hunter, 21, pitched her on it, and she was immediately game. “I was enjoying being with them,” Simson says, “and I was always somebody into things a little bit zany anyway.”
They film her practicing at their local recreation center then share the edited videos on the Instagram and TikTok accounts of their basketball accessory brand, Court Candy, which they founded in the summer of 2020. They are aiming to produce at least 50 videos of her, presenting it as a series with each titled “Grandma to the WNBA.” Simson voices over her footage, using Gen Z phrases like, “I’m strapped,” “I started cooking,” and “chef Curry with the pot, boy.”
“I don’t know what it means, but they don’t understand lingo from my era,” she says.
The project is aspirational, of course. Simson’s grandchildren hoped it would bring more awareness to their company. But it was also a way for her to get in better shape after undergoing a left knee replacement last March. Most importantly to the trio, it allows them to spend more time together.
“She’s one of our best friends, genuinely,” Parker says.
Simson last played recreational basketball in nursing school six decades earlier. In her first workout back, she struggled. “I was hopeless,” she says. “I couldn’t dribble. I couldn’t get it to the basket, unless I was doing it granny style.” That didn’t deter her, however. Nor did it turn off consumers. Her progress has subsequently attracted the attention of millions.
The series debut received nearly 2 million views on TikTok alone. Three other videos have gotten more than a million views on the social media platform. Three videos on Instagram have crossed the 500,000-view plateau. Simson says she doesn’t really understand social media. “I don’t have enough time in my life to do all that,” she says. Nevertheless, she appreciates that people have followed along. Parker and Hunter frequently show her the comments. “We think that’s the coolest part for her,” Parker says. They are overwhelmingly positive. “I’m delighted that people have taken interest because one of the main factors is, if you’re moving, you’re grooving,” Simson says.
Her workouts start earlier than any standard WNBA or college practice. On training days, Simson wakes up at around 5:30 a.m. and begins getting ready. By 7 a.m., she’s on the court, outfitted not only in her grandchildren’s accessory brand but also their basketball sneakers, which she wears only after putting on two pairs of socks and inserting an extra in-sole. Her grandchildren run her through her drills, like two-ball dribbling and pin-down shooting. She practices both underhand and overhand jumpers. She’s still using an eight-foot hoop; they hope to eventually reach WNBA regulation.

In one video, Simson pushes away her walker. In another, she lifts free weights and does split lunges. She practices her vertical jump — it’s 0.67 inches — and completes a three-cone drill in just over six seconds. Multiple videos show her racing through a step ladder, sometimes with a basketball, which she says is among the most difficult exercises. “Baba, you’re 84-years-old. You’re doing great,” her grandchildren tell her when she struggles.
The WNBA has started taking notice of Simson. In December, the Connecticut Sun commented “Grandma… where you at?”
“That was like holy crap,” Hunter says. Soon after, and following Simson’s urging during a video itself, the league’s official account left eye-emojis on its Instagram and TikTok content. Liberty star Breanna Stewart even shared a video of Simson on her Instagram story.
Still, the Simsons’ Las Vegas adventure didn’t exactly pan out as they hoped. Without an appointment, Parker says a security guard at the Aces facility turned them away. Instead, they filmed a video on the sidewalk outside.
The Simson grandchildren hope the project creates more opportunities for “Grandma Shirley,” who they recently launched a separate Instagram page for. It’s called “EasyMoneyGranny,” a play on Kevin Durant’s “easymoneysniper” handle.
They’d love to see her receive an invite to a WNBA All-Star Game or for her to play a ceremonial role at the draft. “We just want to have it lead to some cool adventures for her,” Parker says.
That prospect excites Simson, though it produces some worries too. She’s asked her grandsons: “What if somebody wants me to actually come and then I’m not good enough? What if a team takes me and I play lousy?”
They respond: “Baba, don’t worry, they’re not gonna expect you to be dunking and doing crazy stuff.”
It also doesn’t help quell any nerves that a family vacation and a holiday cold temporarily halted Simson’s workouts. But having recovered and settled back in at home in British Columbia, her journey to the WNBA will continue.
“Those of us who are fortunate enough to still be alive, we should show people that old people can do things and old people can have dreams,” Simson says. “Though we might forget a lot, we sure know how to do a lot too.” (The Athletic).
If you want to see videos of Shirley training and playing, click here.
____________________________________________